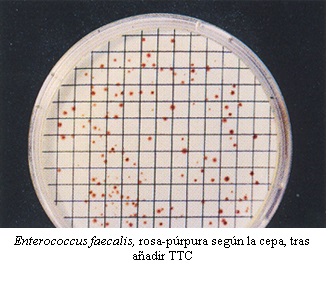

Cepas de Enterococos fecales, cuantitativas, para control de los medios ISO 7899 de aguas: E.faecalis y E.faecium
Cepas de Enterococos fecales
Los enterococos fecales son un subgrupo que se apartó hace unos años de los estreptococos fecales, aunque ambos son indicadores de lo mismo: Infiltración de aguas fecales. Son cocos Gram positivos, que se agrupan en cadenas en forma de rosarios y cuya principal característica distintiva, es que son catalasa negativos (no burbujean al añadirles reactivo para catalasa), a diferencia de los demás microorganismos aerobios y facultativos más habituales que buscamos en los laboratorios de aguas, alimentos…
Son un excelente indicador de lo mismo que indica E.coli: infiltración de aguas residuales en la red de potables.
A menudo procedentes de granjas animales o de animales salvajes (raro es el pozo o fuente natural que no los contenga), su ventaja sobre E.coli como indicador es que perduran en el agua durante muchos días, incluso semanas, por lo que son capaces de advertirnos de la contaminación provocada hace más tiempo que lo que nos permite saber E.coli (que normalmente dura 1 día o poco más en el agua).
Para saber más, incluido el método rápido validado por MICROKIT para conocer la presencia/ausencia y recuento de enterococos fecales en sólo 18 horas, lea nuestra monografía:
https://www.medioscultivo.com/enterococos-fecales-mejoras-en-su-deteccion/
Cepas disponibles en stock para entrega inmediata
MICROKIT pone a su disposición 2 cepas cuantitativas de Enterococos fecales en formato lentícula estabilizada, con el doble de vida útil que la mayoría de cepas cuantitativas (en nuestro caso, 2 años de caducidad desde fabricación):
WDCM 00087 (E.faecalis),
WDCM 00178 (E.faecium)
Todas ellas con excelente capacidad de conservación, dado que las fabricamos con un sistema que no las maltrata, como lo hace la liofilización.
Medios de cultivo para detectar/enumerar Enterococos fecales
Los medios más usados para su aislamiento en placa, por su mención en las Normas ISO, son el SB (Slanetz-Bartley) y el BEA (Bilis Esculina Azida):
https://www.microkit.es/fichas/SLANETZ-BARTLEY-M-ENTEROCOCCUS-TTC-AGAR.pdf
https://www.microkit.es/fichas/BILE-ESCULIN-AZIDE-AGAR-BEA-RAPID.pdf
Tambien merece mención el KAA en alimentos:
https://www.microkit.es/fichas/KAA-AGAR.pdf
así como los cromogénicos validados por la EPA, con colonias azules (que en nuestra experiencia no son tan selectivos como el Rapid BEA de MICROKIT):
https://www.microkit.es/fichas/CROMOKIT-ENTEROCOCCUS-EPA-AGAR.pdf
Su confirmación directa en los agares selectivos es muy sencilla:

Catalasa positivo de la mayoría de microorganismos aerobios y facultativos. En cambio los enterococos fecales no provocan esta efervescencia cuando se añade sobre sus colonias el reactivo para la catalasa.
Para identificar la especie, dispone de las galerías enzimáticas rápidas (le dicen la especie en sólo 4 horas) RAPID-STR:
https://www.microkit.es/fichas/Galerias-RAPID.pdf
Así, además, podrá distinguir los enterococos fecales de los estreptococos fecales y de otras cepas
Contacto
Todas estas cepas mencionadas (y otras muchas), así como todos los medios de cultivo, reactivos y galerías mencionados, los tenemos en nuestras instalaciones en stock para entrega inmediata. Solicite la lista actualizada de stock de cepas cuantitativas para consultar las concentraciones y caducidades, antes de realizar sus pedidos, en microkit@microkit.es.
Consulte el folleto:
https://www.microkit.es/pdf/CEPAS-CUANTITATIVAS-2022.pdf
y el video:
Solicite asesoría técnica sobre qué cepas de Enterococos fecales funcionarán mejor en sus muestras y cómo debe y no debe buscarlas, (según los resultados de 2 décadas de servicios intercomparativos) y en sus validaciones en: consultastecnicas@microkit.es
Haga sus pedidos de cepas en: pedidos@microkit.es
Cepas cuantitativas de MICROKIT, la únicas lentículas cuantitativas fabricadas en España, desde hace más de 15 años, bajo Norma ISO 9001 y siguiendo las directrices sobre la competencia de los fabricantes de material de referencia (ISO 17034).